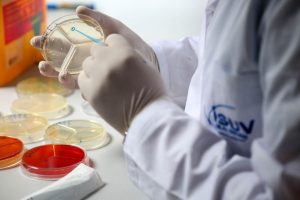

Instituti i Sigurisë Ushqimore dhe Veterinarisë ka akredituar gjatë këtij viti 49 teste të reja analizash nga 53 të tilla që ka pasur deri në vitin 2019.
Ministri i Bujqësisë dhe Zhvillimit Rural, Bledi Çuçi, bëri një vizitë në këtë institucion të rëndësishëm për sigurinë ushqimore në vend, si dhe u takua me personelin që punon aty. Sipas drejtorit të ISUV, Armand Reveli, 49 testet e reja i shërbejnë planit kombëtar të monitormit, rekomandimeve të Brukselit dhe mbështetjes së eksportit të produkteve bujqësore.
“Zgjerimi i këtyre testeve të reja do të thotë besueshmëri e rezultatit karshi biznesit dhe besueshmëri karshi konsumatorit për sigurinë ushqimore”, tha Reveli.
Testet e akredituara janë indikatori i matjes së besueshmërisë së rezultatit lidhur me kontrollet mbi cilësinë e produkteve dhe nënprodukteve shqiptare ose atyre të importuara. Konkretisht këto teste të reja përfshijnë kontrollin e mbetjeve të pesticideve në produktet me origjinë bimore dhe shtazore.
Përmes tyre identifikohen Histamina, Aflatoksina, Salmoneloza, Enterobakteret, metalet e ndryshme, aciditeti i vajit të ullirit etj.
Ndërkohë veç akreditimit të 49 testeve të reja, ka përfunduar së fundi edhe rikonstruksioni i plotë i Laboratorit për Analizat e Sigurisë Ushqimore në ISUV, falë një investimi rreth 33 milionë lekë të qeverisë shqiptare. Laboratori i ri është me kushte dhe standarde sipas kërkesave të Bashkimit Europian.